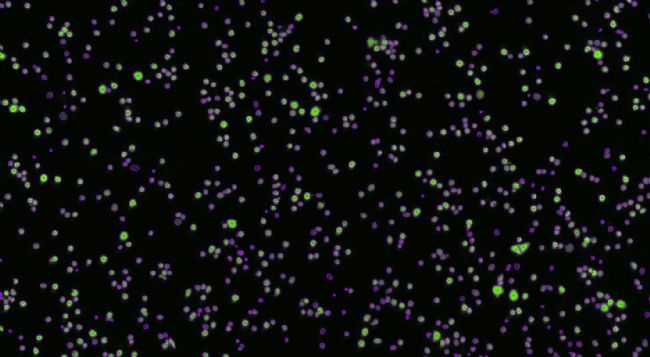

一睹免疫細(xì)胞搏殺戰(zhàn)場(chǎng)的風(fēng)采
效應(yīng)細(xì)胞功能鑒定和抗體藥物研發(fā)之ADCC分析
(Celigo全視野細(xì)胞掃描分析儀)

1.ADCC作用
ADCC作用即抗體依賴(lài)細(xì)胞介導(dǎo)的細(xì)胞毒性作用(antibody-dependent cell-mediated cytotoxicity):指表達(dá)IgGFc受體的NK細(xì)胞、巨噬細(xì)胞和中性粒細(xì)胞等,通過(guò)與已結(jié)合在病毒感染細(xì)胞和腫瘤細(xì)胞等靶細(xì)胞表面的IgG抗體的Fc段結(jié)合,而達(dá)到殺傷這些靶細(xì)胞的作用。
2.ADCC作用的關(guān)鍵點(diǎn)
3.檢測(cè)方法:
全視野細(xì)胞掃描分析儀能多時(shí)間點(diǎn)圖像監(jiān)測(cè)和定量分析效應(yīng)細(xì)胞殺死靶細(xì)胞的搏殺戰(zhàn)場(chǎng)。
4.Celigo監(jiān)測(cè)實(shí)驗(yàn)流程舉例
1)Calcein AM熒光染料:一種可對(duì)活細(xì)胞進(jìn)行熒光標(biāo)記的細(xì)胞染色試劑。
Calcein AM能夠輕易穿透活細(xì)胞膜,進(jìn)入到細(xì)胞質(zhì)后,酯酶會(huì)將其水解為Calcein(鈣黃綠素)留在細(xì)胞內(nèi),發(fā)出強(qiáng)綠色熒光。因?yàn)槠浼?xì)胞毒性低,是最適合作為活細(xì)胞的熒光探針。
1.)ADCC分析流程:

5.Celigo成像
1) 0h靶細(xì)胞全孔圖像 綠色熒光圖像 明場(chǎng)+熒光疊加
2)0h靶細(xì)胞計(jì)數(shù)圖像(取局部圖像)
綠色熒光細(xì)胞圖像 圈定的計(jì)數(shù)的細(xì)胞圖像
3)不同時(shí)間點(diǎn)靶細(xì)胞計(jì)數(shù)圖像
0h 2h 4h 6h

6.ADCC殺傷公式和殺傷曲線

CAM+_t0: 0h的Calcein AM陽(yáng)性數(shù) nCAM+_t: t小時(shí)的Calcein AM陽(yáng)性數(shù)
ADCC殺傷曲線

7.基于Celigo圖像的Calcein AM法和LDH釋放法對(duì)比

8.不同效靶比(E:T)對(duì)ADCC作用的影響
10:1 5:1 2.5:1

1.3:1 0.6:1 0.3:1

9.不同效應(yīng)時(shí)間點(diǎn)搏殺的細(xì)胞圖像
|
t=0h
|
|
t=2h
|
|
t=4h
|
|
t=6h
|
10.不同抗體濃度搏殺的細(xì)胞圖像
|
0g/ml, 6h
|
|
100pg/ml, 6h
|
|
10ng/ml, 6h
|
|
1 µg/ml, 6 h
|
詳細(xì)信息請(qǐng)咨詢(xún):
達(dá)科為生物技術(shù)有限公司
聯(lián)系人:肖女士
電話:0755-26410151
郵箱:equipment@
網(wǎng)址:www.